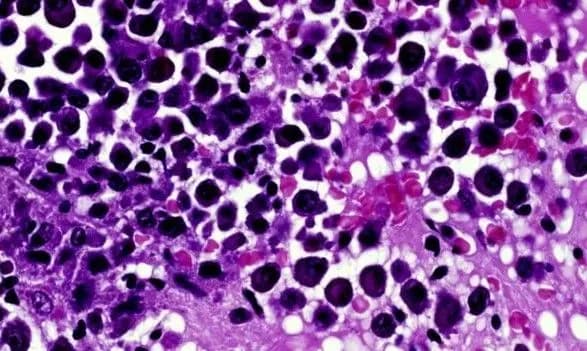
Новые лекарства позволят нейтрализовать самые стойкие раковые клетки

Новые лекарства позволят нейтрализовать самые стойкие раковые клетки
Киев • УНН
КИЕВ. 18 мая. УНН. Британские исследователи говорят, что уже в течение ближайших 10 лет могут быть разработаны новые препараты, способные останавливать развитие даже самых стойких раковых клеток, которые не реагируют на другие процедуры. Об этом сообщает УНН со ссылкой на ВВС.
Британский Институт исследования рака (ICR) объявил, что выделяет на изучение этого подхода более 95 млн долларов.
ICR надеется открыть современный центр разработки новых лекарств в лондонском районе Саттон, на юге столицы.
Глава института Пол Воркмен говорит, что самой большой проблемой в борьбе с раком остается способность раковых клеток адаптироваться к лекарствам и выработать к ним стойкость.
По его словам, новые препараты, которые сейчас находятся на стадии разработки, смогут сдерживать распространение рака в долгосрочной перспективе. Кроме того, от рака можно будет излечиваться гораздо чаще.
Напомним, начиная с лета, в Украине можно будет бесплатно получить направление на прохождение скрининговых исследований на наличие онкологических заболеваний.